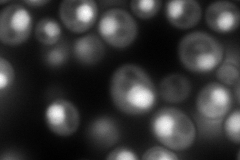
YOR185C
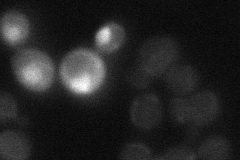
YOR185C
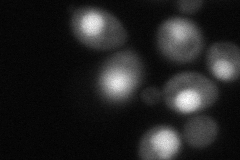
YOR185C
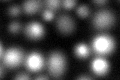
YOR185C
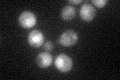
YOR185C
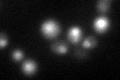
YOR185C

View description
GTP binding protein (mammalian Ranp homolog) involved in the maintenance of nuclear organization, RNA processing and transport; interacts with Kap121p, Kap123p and Pdr6p (karyophilin betas); Gsp1p homolog that is not required for viability
Localization:
Intensity:
Fold change:
Significance:
-
C’ GFP library in SD

nucleus:cytosol29.26 -
N' NOP1pr-GFP in SD
nucleus378.952 -
N' TEF2pr-mCherry in SD

nucleus417.103 -
N' NATIVEpr-GFP in SD
cytosol,nucleus14.5666 -
N' TEF2pr-VC and Cyto-VN in SD
nucleus95.8101 -
C’ GFP library in SD+DTT
nucleus.cytosol46.151.57Yes -
C’ GFP library in SD+H2O2
nucleus.cytosol44.591.52Yes -
C’ GFP library in Starvation Media
nucleus,cytosol98.563.36Yes -
C’ GFP library on the background of Pup2-DaMP

nucleus:cytosol -
C’ GFP library on the background of CCT mutant

nucleus:cytosol23.33770.79743No
